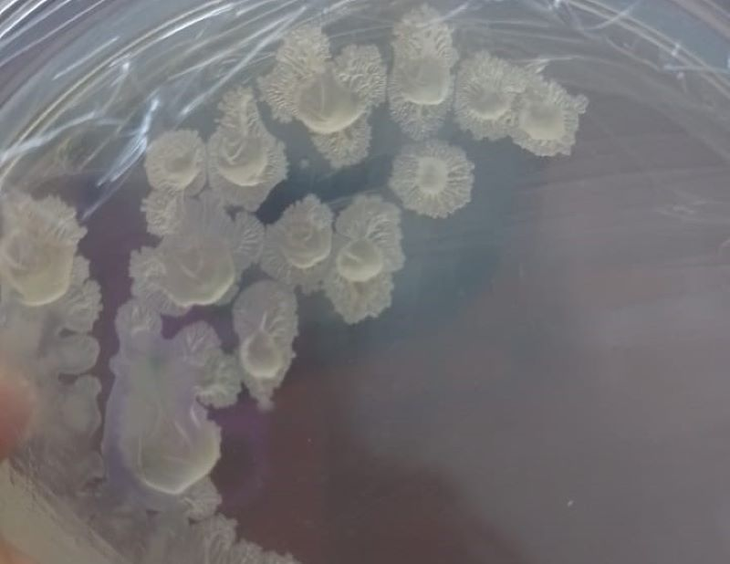
En el INTA investigan una bacteria. Foto: INTA En el INTA investigan una bacteria. Foto: INTA

Estudian una bacteria que mejora la calidad de suelos degradados
Un equipo de investigación –integrado por especialistas del INTA Salta, Conicet y la Universidad Nacional de Salta (UNSa)– determinó que la cepa Bacillus amyloliquefaciens reduce la pudrición de raíces y tallos en poroto en un sistema agrícola degradado en el Valle de Lerma.
El poroto común es un cultivo estratégico con gran relevancia para la economía regional en el noroeste argentino, debido a que el 90% de su producción se destina a exportación. Por esto, es clave investigar estrategias que aseguren su rendimiento, calidad y rentabilidad para que pueda estar disponible en los mercados que lo demanden.
Sin embargo, esta búsqueda para satisfacer las necesidades nutricionales del monocultivo de poroto también derivó en la paulatina degradación de los suelos productivos, lo que redujo el contenido de carbono y nutrientes asociados, como así también alteró la calidad físico-química del suelo y en consecuencia su salud biológica.
“Una de las consecuencias directas de este tipo de eventos es la perturbación de la diversidad microbiológica del suelo; dicha diversidad es clave para una buena salud edáfica”, expresó Carolina Pérez Brandan, investigadora del INTA Salta, quien aseguró que esa biodiversidad “cumple un rol fundamental en la regulación de procesos que determinan funciones del ecosistema que están relacionadas con la producción de biomasa, el ciclo de nutrientes, mantenimiento y mejora del microbioma del suelo, como así también con la supresión de enfermedades de las plantas y estabilidad de los agregados del suelo, entre otras funciones”.
Por esto, el estudio se enfocó en “evaluar la capacidad de la cepa Bacillus amyloliquefaciens (B14) para mejorar la calidad de un suelo degradado en el Valle de Lerma”, indicó Pérez Brandan y agregó: “A su vez, buscamos determinar su incidencia en el crecimiento y rendimiento del poroto común negro, inoculando las semillas del cultivo con esta cepa”.
Los efectos de esta cepa fueron comparados con el de un agroquímico comúnmente utilizado en la región. “Los resultados demostraron que la cepa Bacillus amyloliquefaciens mejoró la disponibilidad de nutrientes, aumentó el carbono orgánico del suelo, nitrógeno total y fósforo extraíble. Además, la cepa B14 aumentó la actividad enzimática del suelo, respiración microbiana y carbono de biomasa microbiana”, destacó la investigadora.
Macrophomina phaseolina es un hongo fitopatógeno que causa la podredumbre radicular cultivo de poroto, pudiendo disminuir hasta en un 80 % el rendimiento. En este sentido, “también se evaluó un suelo infectado con Macrophomina dado que, en una investigación previa, se descubrió que B. amyloliquefaciens tiene un efecto antagónico contra este hongo patógeno”, agregó la investigadora.
Por otro lado, esta cepa aumentó significativamente la presencia de determinados agentes de control biológico como: Trichoderma spp., Gliocladium spp., Pseudomonas spp. y actinomicetos en el suelo; “mostrando un efecto mayor que el del agroquímico”, sostuvo Pérez Brandan.
Por lo tanto, la cepa B. amyloliquefaciens es un bioinoculante potencial para porotos en el noroeste Argentina, donde no sólo podrá mejorar y proteger el cultivo de frijol común, sino también mejorar la calidad y salud del suelo.
Fuente: INTA
En esta nota